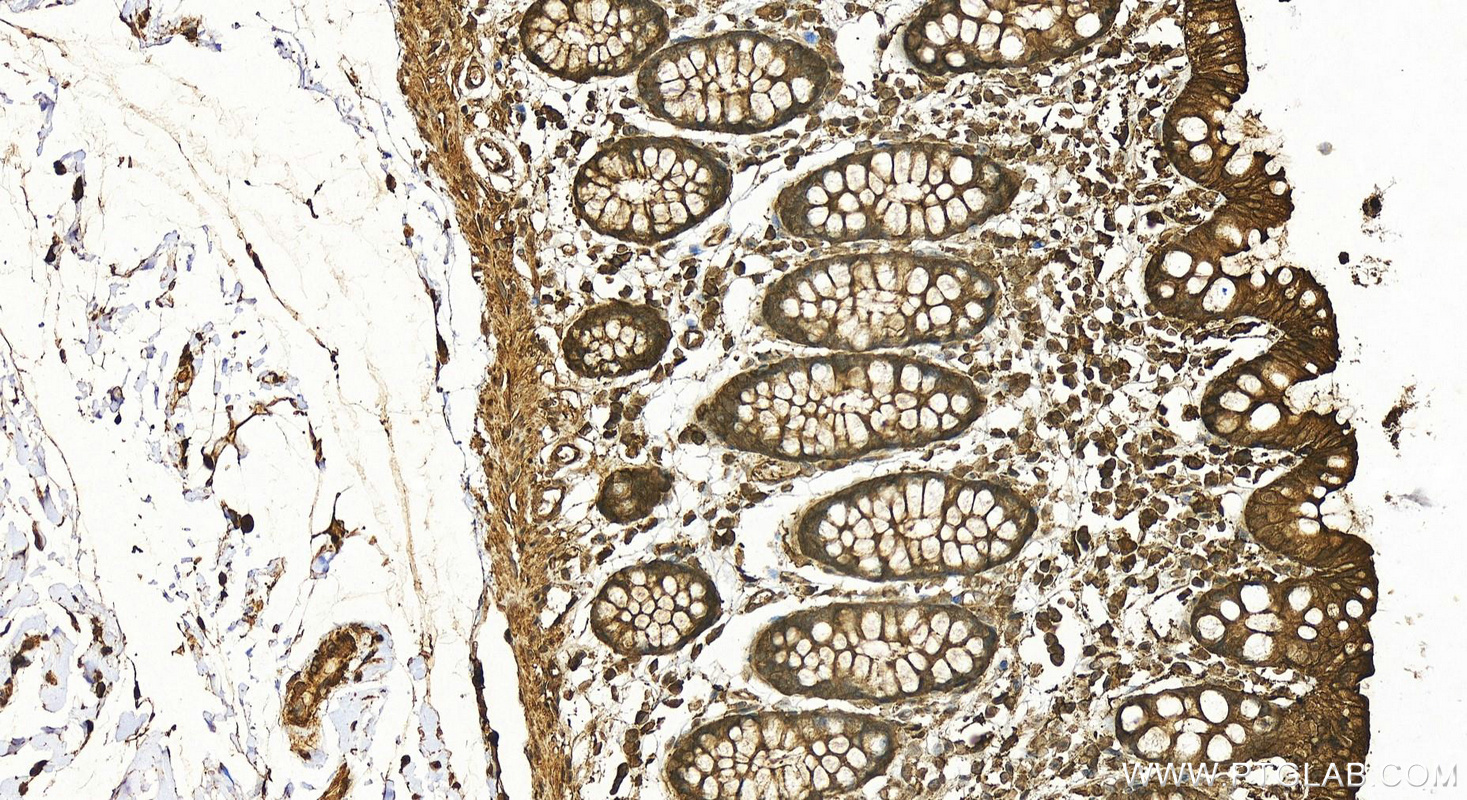

验证数据展示
经过测试的应用
| Positive WB detected in | HEK-293 cells, A549 cells, C6 cells, mouse colon tissue, Caco-2 cells, RAW 264.7 cells, SMMC-7721 cells, HeLa cells, HepG2 cells, Jurkat cells, mouse brain tissue, rat brain tissue, NIH/3T3 cells, mouse liver tissue, rat kidney tissue, rat spleen tissue, rat liver tissue |
| Positive IHC detected in | human colon tissue, human kidney tissue Note: suggested antigen retrieval with TE buffer pH 9.0; (*) Alternatively, antigen retrieval may be performed with citrate buffer pH 6.0 |
| Positive IF/ICC detected in | MDCK cells |
推荐稀释比
| 应用 | 推荐稀释比 |
|---|---|
| Western Blot (WB) | WB : 1:4000-1:10000 |
| Immunohistochemistry (IHC) | IHC : 1:50-1:500 |
| Immunofluorescence (IF)/ICC | IF/ICC : 1:200-1:800 |
| It is recommended that this reagent should be titrated in each testing system to obtain optimal results. | |
| Sample-dependent, Check data in validation data gallery. | |
产品信息
20536-1-AP targets Beta Actin in WB, IHC, IF/ICC, IP, CoIP, ELISA applications and shows reactivity with human, mouse, rat, canine, monkey samples.
| 经测试应用 | WB, IHC, IF/ICC, ELISA Application Description |
| 文献引用应用 | WB, IHC, IF, IP, CoIP, ELISA |
| 经测试反应性 | human, mouse, rat, canine, monkey |
| 文献引用反应性 | human, mouse, rat, chicken, goat, sheep, yeast, ochotona curzoniae, camelus bactrianus, carp |
| 免疫原 |
CatNo: Ag14521 Product name: Recombinant human beta actin protein Source: e coli.-derived, PGEX-4T Tag: GST Domain: 1-50 aa of BC002409 Sequence: MDDDIAALVVDNGSGMCKAGFAGDDAPRAVFPSIVGRPRHQGVMVGMGQK 种属同源性预测 |
| 宿主/亚型 | Rabbit / IgG |
| 抗体类别 | Polyclonal |
| 产品类型 | Antibody |
| 全称 | actin, beta |
| 别名 | Actin, ACTB, bate actin, β actin, Beta-actin |
| 计算分子量 | 375 aa, 42 kDa |
| 观测分子量 | 42 kDa |
| GenBank蛋白编号 | BC002409 |
| 基因名称 | Beta Actin |
| Gene ID (NCBI) | 60 |
| RRID | AB_10700003 |
| 偶联类型 | Unconjugated |
| 形式 | Liquid |
| 纯化方式 | Antigen affinity purification |
| UNIPROT ID | P60709 |
| 储存缓冲液 | PBS with 0.02% sodium azide and 50% glycerol, pH 7.3. |
| 储存条件 | Store at -20°C. Stable for one year after shipment. Aliquoting is unnecessary for -20oC storage. |
背景介绍
Beta Actin, also named as ACTB and F-Actin, belongs to the actin family. Actins are highly conserved globular proteins that are involved in various types of cell motility and are ubiquitously expressed in all eukaryotic cells. At least six isoforms of actins are known in mammals and other vertebrates: alpha (ACTC1, cardiac muscle 1), alpha 1 (ACTA1, skeletal muscle) and 2 (ACTA2, aortic smooth muscle), beta (ACTB), gamma 1 (ACTG1) and 2 (ACTG2, enteric smooth muscle). Beta and gamma 1 are two non-muscle actin proteins. Most actins consist of 376aa, while ACTG2 (rich in muscles) has 375aa and ACTG1(found in non-muscle cells) has only 374aa. Beta actin has been widely used as the internal control in RT-PCR and Western Blotting as a 42-kDa protein. However, the 37-40, 31, 15 kDa cleaved fragment of beta actin can be generated during apoptosis process. This antibody was generated against N-terminal region of human beta actin protein and can cross-react with other actins. (9173887, 11217076, 10229193 )
实验方案
| Product Specific Protocols | |
|---|---|
| IF protocol for Beta Actin antibody 20536-1-AP | Download protocol |
| IHC protocol for Beta Actin antibody 20536-1-AP | Download protocol |
| WB protocol for Beta Actin antibody 20536-1-AP | Download protocol |
| Standard Protocols | |
|---|---|
| Click here to view our Standard Protocols |
发表文章
| Species | Application | Title |
|---|---|---|
Cancer Cell Targeting the immune privilege of tumor-initiating cells to enhance cancer immunotherapy | ||
Nature Aspm knockout ferret reveals an evolutionary mechanism governing cerebral cortical size. | ||
Signal Transduct Target Ther Identifying genetic targets in clinical subtypes of Parkinson's disease for optimizing pharmacological treatment strategies | ||
Cell Microglia jointly degrade fibrillar alpha-synuclein cargo by distribution through tunneling nanotubes. |